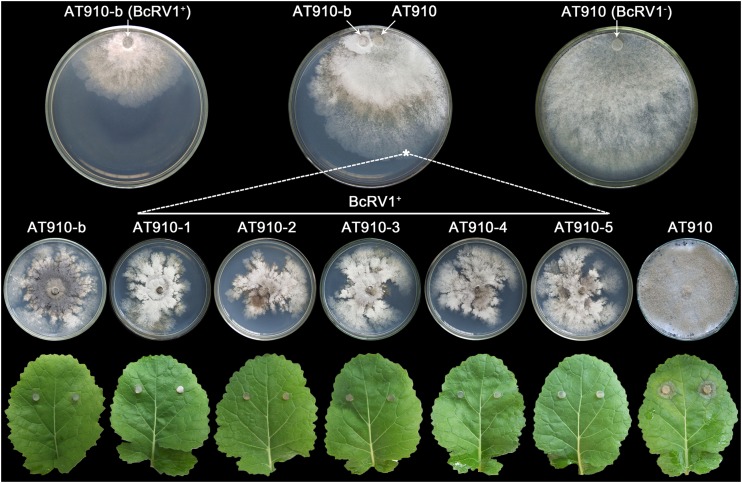

Abstract
Botrytis cinerea is a pathogenic fungus causing gray mold on numerous economically important crops and ornamental plants. This study was conducted to characterize the biological and molecular features of a novel RNA mycovirus, Botrytis cinerea RNA virus 1 (BcRV1), in the hypovirulent strain BerBc-1 of B. cinerea. The genome of BcRV1 is 8,952 bp long with two putative overlapped open reading frames (ORFs), ORF1 and ORF2, coding for a hypothetical polypeptide (P1) and RNA-dependent RNA polymerase (RdRp), respectively. A −1 frameshifting region (designated the KNOT element) containing a shifty heptamer, a heptanucleotide spacer, and an H-type pseudoknot was predicted in the junction region of ORF1 and ORF2. The −1 frameshifting role of the KNOT element was experimentally confirmed through determination of the production of the fusion protein red fluorescent protein (RFP)-green fluorescent protein (GFP) by the plasmid containing the construct dsRed-KNOT-eGFP in Escherichia coli. BcRV1 belongs to a taxonomically unassigned double-stranded RNA (dsRNA) mycovirus group. It is closely related to grapevine-associated totivirus 2 and Sclerotinia sclerotiorum nonsegmented virus L. BcRV1 in strain BerBc-1 was found capable of being transmitted vertically through macroconidia and horizontally to other B. cinerea strains through hyphal contact. The presence of BcRV1 was found to be positively correlated with hypovirulence in B. cinerea, with the attenuation effects of BcRV1 on mycelial growth and pathogenicity being greatly affected by the accumulation level of BcRV1.
INTRODUCTION
Mycoviruses, or fungal viruses, are viruses infecting filamentous fungi and yeasts (1, 2). Most mycoviruses reported so far are either positive-single-stranded RNA (+ssRNA) viruses, including mycoviruses in the families Hypoviridae and Narnaviridae, or double-stranded RNA (dsRNA) viruses, including mycoviruses in the families Chrysoviridae, Megabirnaviridae, Partitiviridae, Reoviridae, and Totiviridae (1, 3). Recently, mycoviruses with negative-single-stranded RNA genomes (−ssRNA) were reported (4, 5). Moreover, Yu et al. (6) reported a single-stranded DNA (ssDNA) mycovirus, namely, Sclerotinia sclerotiorum hypovirulence-associated DNA virus 1 (SsHADV-1), in Sclerotinia sclerotiorum, the causal agent of Sclerotinia stem rot of oilseed rape (Brassica napus).
Mycoviruses are widespread in all major taxonomic groups of fungi, including many plant pathogens (2). In most cases, mycovirus infection appears symptomless on the host fungi, usually called a latent or cryptic infection (1). However, infection by some mycoviruses in the families Hypoviridae, Megabirnaviridae, Narnaviridae, Partitiviridae, and Reoviridae or by the unassigned −ssRNA and ssDNA mycoviruses can cause visible abnormal symptoms on the host fungi, including reduced mycelial growth, reduced production of spores and/or sclerotia, suppressed biosynthesis of secondary metabolites, and attenuated aggressiveness or virulence (2, 3, 5–7). Some hypovirulence-causing mycoviruses have been reported to be promising agents for control of plant-pathogenic fungi such as the +ssRNA mycovirus Cryphonectria hypovirus 1 (CHV1) against Cryphonectria parasitica (8, 9), the causal agent of chestnut blight, and the ssDNA mycovirus SsHADV-1 against S. sclerotiorum (6, 10). Moreover, detailed studies on interactions between mycoviruses and fungal hosts can provide novel insights into molecular mechanisms involved in the pathogenesis of plant-pathogenic fungi (7).
Botrytis cinerea Pers.: Fr. [teleomorph: Botryotinia fuckeliana (de Bary) Whetzel] is a ubiquitous phytopathogenic fungus causing gray mold disease. It infects leaves, stems, blossoms, and/or fruits of more than 200 plant species, including ornamentals (e.g., carnation, rose), vegetables (e.g., tomato, cucumber), fruits (e.g., grapes, strawberry), and some field crops (e.g., oilseed rape), resulting in substantial economic losses (11). Given the importance of B. cinerea and the problems of fungicide resistance and residues, the possibility of using mycoviruses as biological control agents has attracted the interest of many researchers (12, 13).
Mycoviruses are common in B. cinerea (14–24). A few RNA mycoviruses in B. cinerea have been sequenced (17, 18, 20, 23, 24). They include +ssRNA mycoviruses, such as Botrytis cinerea mitovirus 1 (BcMV1; GenBank accession no. EF580100), Botrytis virus F (BVF; AF238884), and Botrytis virus X (BVX; AY055762), and dsRNA mycoviruses, such as Botrytis cinerea CCg378 virus 1 (Bc378V1; KF201714), Botryotinia fuckeliana totivirus 1 (BfTV1; AM491608), and Botryotinia fuckeliana partitivirus 1 (BfPV1; AM491609 and AM491610). Among these mycoviruses, BcMV1 is closely associated with hypovirulence of B. cinerea (23, 24). Moreover, Xiao et al. (25) reported that the dsRNA mycovirus Sclerotinia sclerotiorum partitivirus 1 (SsPV1) in strain WF-1 of S. sclerotiorum can infect B. cinerea, resulting in reduced virulence, suppressed mycelial growth, and inhibited elongation of conidial germ tubes.
Previous studies showed that vegetative incompatibility is an obstacle to the application of mycoviruses as biological control agents in controlling plant fungal diseases, as it restricts transmission of mycoviruses from mycovirus-infected strains to mycovirus-free strains through hyphal contact or anastomosis (8, 9). Vegetative incompatibility has been detected in populations of B. cinerea (26, 27). Wu et al. (23, 24) reported that through hyphal contact, BcMV1 could be transmitted to single-conidium (SC) virulent isolates of B. cinerea strain CanBc-1, from which BcMV1 was originally isolated, but could not be transmitted to a different virulent strain, CanBc-2, of B. cinerea. Therefore, screening of mycoviruses capable of overcoming hyphal incompatibility in transmission is a prerequisite for applications of mycoviruses to control B. cinerea. Previous studies also showed that hyphal incompatibility cannot restrict horizontal transmission of the mycoviruses in C. parasitica and the basidiomycetous fungus Heterobasidion annosum (28–30).
A hypovirulent strain of B. cinerea designated strain BerBc-1 was isolated from a Berberis sp. in Wuhan, China. A dsRNA element of approximately 10 kb in size was detected in strain BerBc-1, here designated Botrytis cinerea RNA virus 1 (BcRV1). According to a recent review by Pearson and Bailey (13), dsRNA elements or mycoviruses in B. cinerea of such large size have not been previously characterized either at the biological level or at the molecular level (14, 15, 17, 18, 20, 23, 24). It might represent the genome of a novel mycovirus in B. cinerea. Therefore, we conducted this study to fulfill the following three objectives: (i) to characterize the molecular properties of BcRV1, (ii) to determine the transmissibility of BcRV1, and (iii) to investigate the effects of BcRV1 on the pathogenicity of B. cinerea.
MATERIALS AND METHODS
Fungal strains.
Strains BerBc-1, LagBc-1, and RoseBc-3 of B. cinerea used in this study were isolated in Wuhan, China, from Berberis sp. in 2008, Lagenaria siceraria in 2009, and Rosa chinensis in 2004, respectively. They were stored in a 20% (vol/vol) glycerol solution at −80°C.
Extraction and identification of dsRNA.
Mycelia of each strain of B. cinerea were collected from 3-day-old cultures (20°C) on autoclaved cellophane films placed on potato dextrose agar (PDA) in petri dishes and stored at −80°C until use. dsRNA was extracted, purified from the mycelia using the procedures described by Wu et al. (23), and detected by agarose gel (1%, wt/vol) electrophoresis (23). The nature of the dsRNA was confirmed by digestion of the extracts with RNase A (TaKaRa Biotechnology Co., Ltd., Dalian, China), RQ1 RNase-free DNase (Promega, Madison, WI, USA), and S1 nuclease (TaKaRa) (23, 24, 31). The molecules that can be digested by RNase A but not by DNase and S1 nuclease were considered to be dsRNAs (23, 24, 31).
Extraction of total RNA and genomic DNA.
Total RNA was extracted from 3-day-old mycelia (20°C) of each strain of B. cinerea using the RNAiso Plus kit (TaKaRa) according to the procedures recommended by the manufacturer. It was purified by removing the contaminating DNA with RQ1 RNase-free DNase (Promega). The concentration of the purified RNA (1.8 < A260/280 < 2.0) was estimated with a BioPhotometer Plus photometer (Eppendorf, Germany). The RNA extract was dissolved in diethyl pyrocarbonate (DEPC)-H2O and stored at −80°C until use.
Genomic DNA was extracted from 2-day-old mycelia (20°C) of each strain using the minipreparation procedures described by Möller et al. (32). It was purified by removing contaminating RNA with RNase A (TaKaRa). The DNA extract was dissolved in distilled water and stored at −20°C until use.
cDNA cloning of BcRV1.
The dsRNA extracted from strain BerBc-1 was gel purified using the AxyPrep DNA gel extraction kit (Axygen Scientific Inc., Union City, CA, USA). For construction of a cDNA library of the 10-kb dsRNA element, approximately 200 ng purified dsRNA was mixed with 15 μM tagged random hexameric primer RACE3RT (see Table S1 in the supplemental material), 2 μl pure dimethyl sulfoxide, 1 μl 10 mM deoxynucleoside triphosphates (dNTPs), and DEPC-H2O to a final volume of 15 μl. The mixture was heated to and maintained at 94°C for 90 s, followed by chilling on ice for 10 min. The mixture was amended with 1 μl RevertAid Premium Enzyme mix and 4 μl 5× reverse transcription (RT) buffer (RevertAid Premium First Strand cDNA synthesis kit; Fermentas, Lithuania) and incubated at 50°C for 90 min for reverse transcription, followed by incubation at 85°C for 5 min to terminate the reaction. Then, NaOH solution was added to a final concentration of 0.1 M, and the mixture was treated at 65°C for 1 h to degrade the remains of the BcRV1 dsRNA. The mixture was neutralized by addition of 2.5 μl HCl (1 M) and 2.5 μl Tris-HCl (1 M, pH 8.0) and maintained at 16°C for 16 h for formation of partial double-stranded cDNAs, which were finally purified using the AxyPrep DNA gel extraction kit (Axygen) and dissolved in 40 μl distilled water. The resulting mixture was supplemented with 2.5 U Taq DNA polymerase (TaKaRa), 5 μl 10× PCR buffer, 4 μl dNTPs (2.5 mM), and ddH2O to a final volume of 50 μl, followed by incubation at 68°C for 30 min to get the complete double-stranded cDNAs. Random cDNA products were then PCR amplified using the primer TAG (see Table S1 in the supplemental material) in an S1000 Thermal Cycler (Bio-Rad) with the following program: one cycle at 95°C for 5 min and 30 cycles at 95°C for 30 s, 60°C for 60 s, and 72°C for 3 min. The amplicons were ligated into the pMD18-T vector (TaKaRa), which was then transformed into competent cells of Escherichia coli DH5α. Positive clones grown on Luria-Bertani agar medium containing ampicillin (50 μg/ml) were selected, and their cDNA insert sizes were checked with PCR using primer set M13F-47/M13R-48 (see Table S1 in the supplemental material). The bacterial colonies with cDNA inserts longer than 500 bp were selected, and the cDNA inserts were sequenced. The resulting cDNA sequences were assembled using the DNAMAN software (version 5.2.2; Lynnon Corp., Vaudreuil, Quebec, Canada). Gaps in sequences between different clones were determined using RT-PCR with sequence-specific primers (see Fig. S1 and Table S1 in the supplemental material).
Cloning of the terminal sequences of BcRV1 was performed using the method described by Wu et al. (24, 31). The 3′ terminus of each dsRNA strand was ligated with the 5′ terminus of the BPA adaptor (see Fig. S1 and Table S1 in the supplemental material) using T4 RNA ligase (TaKaRa) at 16°C for 16 h. The dsRNA was then reverse transcribed to cDNA using the primer RCBPA (see Table S1 in the supplemental material). The resulting cDNA was used as the template for PCR amplification of the 3′- and 5′-terminal sequences using the primer sets RT-F/RCBPA and RCBPA/RT-R (see Table S1 in the supplemental material), respectively, and the PCR products were cloned, sequenced, and assembled. Every nucleotide pair in the cDNA sequence was determined by sequencing at least three clones.
Sequence analysis.
Open reading frames (ORFs) in the full-length cDNA sequence of BcRV1 and polypeptides encoded by the ORFs were deduced using the ORF Finder program in NCBI (http://www.ncbi.nlm.nih.gov/gorf/) with the standard codon usages. The DotKnot program (33) and the VARNAv3-8 program (34) were used to predict the pseudoknot structure with the 100-nucleotide (nt) sequence immediately downstream from the predicted slippery sequence as input. A potential secondary structure of the terminal nucleotide sequences of BcRV1 was predicted using the RNA structure software (version 5.4) (35). The sequences of previously reported mycoviruses and related genes were retrieved from the NCBI GenBank database (http://www.ncbi.nlm.nih.gov/genomes) and used for comparative analysis. Multiple sequence alignments were carried out using the Clustal_X 1.83 program to determine the conserved motifs. A phylogenetic tree was inferred from the amino acid sequence of eight conserved motifs of RNA-dependent RNA polymerase (RdRp) using the maximum likelihood method (model WAG+G+I) in MEGA 5.2.2 and tested with a bootstrap of 1,000 replicates to ascertain the reliability of a given branch pattern in the maximum likelihood tree.
Northern hybridization.
Northern hybridization was performed to verify the authenticity of the cDNA sequence generated from the dsRNA in strain BerBc-1. The dsRNA extracted from strain BerBc-1 was separated by agarose gel (0.8%, wt/vol) electrophoresis and transferred to an Immobilon-Ny+ membrane (Millipore, Bedford, MA, USA) using the procedures described by Wu et al. (31). A 717-bp DNA probe was designed on the basis of the RdRp sequence of BcRV1 (nt 6329 to 7045) and generated by RT-PCR using the primer set RT3F/RT3R (see Table S1 in the supplemental material). The probe was labeled with digoxigenin (DIG)-11-dUTP in the DIG High-Prime DNA labeling and detection starter kit I (Roche Diagnostics GmbH, Roche Applied Science, Mannheim, Germany) and used to hybridize with the dsRNA blotted on the nylon membrane. The hybridization signals were detected by enzymatic immunoassay using the reagents in the kit with the procedures recommended by the manufacturer. dsRNAs extracted from the mycelia of strains LagBc-1 and RoseBc-3 were used as controls in Northern hybridization. The experiment was repeated three times.
Confirmation of −1 frameshifting in E. coli.
Alam et al. (36) and Plant et al. (37) proposed that mRNA pseudoknots might induce −1 frameshifting by pausing the translating ribosomes at the shifty heptamer site. The presence of the heptamer-spacer-pseudoknot structure (hereby termed the KNOT element, nt 4812 to 4871) in the genome of BcRV1 implies that a −1 ribosomal frameshifting might occur in the KNOT region, which may induce ribosomal frameshifting to the −1 reading frame relative to ORF1 (for P1) and read-through to ORF2 (for RdRp), resulting in production of the fusion polypeptide P1-RdRp (see Fig. 2B). To confirm the −1 frameshifting function of the KNOT element in BcRV1, two reporter genes, dsRed, coding for red fluorescent protein (RFP; 29 kDa), and eGFP, coding for green fluorescent protein (GFP; 32 kDa), were used in this experiment. As the stop codon TAG was present in the spacer region of the KNOT element (see Fig. S2A in the supplemental material), a large ORF of dsRed-KNOT-eGFP containing KNOT and the ORFs of dsRed and eGFP without the stop codons were constructed together using the fusion PCR technique (38). The construct has an NdeI restriction site at the 5′ terminus and an NotI restriction site at the 3′ terminus. Both the dsRed-KNOT-eGFP ORF and the plasmid pET-28a(+) were digested by NdeI and NotI (Fermentas), resulting in two large DNA fragments, which were then ligated by T4 DNA ligase (TaKaRa) to form the plasmid pET-28a(+)-RKG (see Fig. S2A in the supplemental material). Two other plasmids, pET-28a(+)-dsRed, containing the ORF of dsRed with the stop codon, and pET-28a(+)-eGFP, containing the ORF of eGFP without the stop codon, were separately constructed and used as controls (see Fig. S2B and C in the supplemental material). The three plasmids were separately transformed into competent cells of E. coli BL21(DE3) (TransGen Biotech Co., Ltd., Beijing, China) using the protocol recommended by the manufacturer. The E. coli cultures in Luria-Bertani liquid medium amended with 50 μg/ml kanamycin were grown with shaking (180 rpm, 37°C). IPTG (isopropyl-β-d-thiogalactopyranoside) was added to a final concentration of 0.1 mM when the cultures reached the logarithmic phase (optical density at 600 nm [OD600] = 0.4 to 0.6). The E. coli cultures without addition of IPTG were used as controls. Both the IPTG-induced and the control cultures of E. coli for each plasmid were further incubated with shaking (150 rpm) at 20°C for 36 h. The E. coli cells in each treatment were harvested by centrifugation (14,000 × g) at room temperature. The pellet was resuspended in a proper volume of SDS sample loading buffer (Ding Guo Changsheng Biotechnology Co. Ltd., Beijing, China), and the tube with the resulting bacterial suspension was treated in a boiling water bath for 10 min. After centrifugation (14,000 × g for 10 min), the supernatant containing the bacterial proteins was fractionated by 8% SDS-PAGE and electrotransferred onto an Immun-Blot polyvinylidene difluoride (PVDF) membrane (Bio-Rad) using Bio-Rad Trans-Blot SD Semi-Dry Transfer Cell. The membrane was treated with the anti-GFP monoclonal antibody (1:5,000) or the anti-RFP monoclonal antibody (1:3,000) (Abbkine Inc., Redlands, CA, USA), followed by development of the membrane in Pierce ECL Western blotting substrate (Thermo, USA). Finally, the protein bands on the membrane were visualized on Bio-Rad Universal Hood II.
FIG 2.
Molecular characteristics of BcRV1. (A) Schematic diagram showing the genetic organization of BcRV1. The coding strand of BcRV1 is 8,952 bp long and comprises two overlapped open reading frames: ORF1 (nt 879 to 4,823) putatively encodes a hypothetical polypeptide P1, and ORF2 (nt 4,805 to 8,887) putatively encodes a polypeptide containing the conserved motifs of RNA-dependent RNA polymerase superfamily 4 (RdRp_4) and the phytoreovirus S7 protein (S7). Note the conserved shifty heptamer (5′-GAAAAAC-3′), the start codon AUG, and the stop codon UAG. (B) Schematic diagram showing three genetic elements (the shifty heptamer, the spacer, and the pseudoknot) in the junction region between ORF1 and ORF2 and deciphering the mechanism for −1 ribosomal frameshifting. (C) Predicted secondary structure of the H-type pseudoknot. (D) Predicted secondary structures of the 3′ terminus and 5′ terminus of BcRV1.
Biological characterization.
Working cultures of B. cinerea were established by transferring a mycelial agar plug in storage onto PDA in a petri dish, and the culture was then incubated at 20°C in the dark for 5 days. Mycelial growth rate and colony morphology on PDA (20°C, in the dark) and pathogenicity on leaves of oilseed rape (20°C, 72 h) were determined using the procedures described in our previous studies (23, 24). In the pathogenicity tests, leaves of oilseed rape were detached from 60-day-old plants of oilseed rape (B. napus cultivar Huashuang No. 5). Mycelial agar plugs (5-mm diameter) excised from the colony margins of the PDA cultures of the investigated strains were used as inoculums. There were five replicates for each strain in determining the cultural characteristics and 12 replicates (12 mycelial agar plugs per strain) in testing pathogenicity.
Quantification of BcRV1 accumulation.
Total RNA was extracted from mycelia of each strain and reverse transcribed using the reverse transcriptase RTAce (Toyobo Life Science, Shanghai, China) with the specific primer set BcRVqF/BcRVqR (see Table S1 in the supplemental material). The resulting product was then used as the template for quantifying the BcRV1 accumulation level using quantitative real-time PCR (qRT-PCR) with the primer set BcRVqF/BcRVqR. The qRT-PCR was carried out with SYBR Premix Ex Taq II (TaKaRa) according to the manufacturer's instructions. The PCR was performed in a Bio-Rad iQ2 Thermocycler with the following program: denaturation at 95°C for 1 min, followed by 40 cycles of 95°C for 10 s, 60°C for 20 s, and 72°C for 30 s. The relative accumulation value of BcRV1 was calculated using the 2−ΔΔCT method, where CT is the threshold cycle (39). Meanwhile, expression of the actin gene in each strain was qRT-PCR quantified with the specific primer set ActF/ActR (see Table S1 in the supplemental material) as a reference. There were three biological replicates for each strain and three technical repeats for each replicate.
Vertical transmission of BcRV1.
Vertical transmission refers to the transmission of hypovirulence-associated mycoviruses from hyphae to the next generation through either sexual or asexual spores (7). The vertical transmission of BcRV1 through conidia was investigated here in the hypovirulent strain BerBc-1. Macroconidia of strain BerBc-1 were harvested from a 15-day-old culture on PDA at 20°C in the dark by flooding the colony with sterile distilled water and dislodging the conidia with a sterile glass rod. The conidium-mycelium suspension was filtered through four layers of sterile cheesecloth to remove mycelial fragments. The resulting conidial suspension was then used for single-conidium isolation using the method described by Wu et al. (23, 31), and a total of 133 SC isolates were obtained. All the single-conidium isolates were first tested for pathogenicity on detached oilseed rape leaves (20°C, 72 h) and grouped into pathogenicity groups based on the average lesion diameters. Eight single-conidium isolates (1C001, 1C002, 1C004, 1C008, 1C011, 1C014, 1C017, and 1C072) representing four pathogenicity groups (A to D) were selected for characterization of growth rates and accumulation of BcRV1. Growth rates were determined on PDA at 20°C in the dark, and quantification of the BcRV1 accumulation was carried out using qRT-PCR with the specific primer set BcRVqF/BcRVqR (see Table S1 in the supplemental material). Strains BerBc-1 and RoseBc-3 were included as controls in these tests.
Horizontal transmission of BcRV1.
Horizontal transmission refers to the transmission of mycoviruses from a fungal strain to other fungal strains through hyphal contact or anastomosis (7). Three strains, i.e., one donor strain, BerBc-1 (BcRV1+), and two recipient strains, 1C001 and RoseBc-3 (both BcRV1−), were used in this experiment, using the pairing culture technique described by Wu et al. (23, 31). In order to facilitate selecting the progenies or mycelia of the recipient strains, the recipient strains (1C001 and RoseBc-3) were first labeled with hygromycin resistance by random insertion of transfer DNA (T-DNA) containing the hygromycin B phosphotransferase (hph) gene using Agrobacterium tumefaciens-mediated transformation (40). Initially, 10 hygromycin-resistant T-DNA transformants were obtained from each recipient strain. After comparison with their respective progenitor strains, transformants AT1C001 and AT910 (both hph+, BcRV1−) were selected, based on their close similarity to their progenitor strains 1C001 and RoseBc-3, respectively, in growth rate, production and yield of conidia/sclerotia, and pathogenicity on oilseed rape (see Fig. S3 in the supplemental material), for the horizontal transmission experiment.
The BcRV1 donor strain BerBc-1 was paired with the recipient strain AT1C001 or AT910 (both hph+, BcRV1−) (see Fig. S4 in the supplemental material). For each donor-recipient combination, there were five replicate petri plates each for the pair cultures, the single culture of donor strain BerBc-1, and the single culture of the recipient strain. After incubation at 20°C in the dark for 7 days, hyphal anastomosis between the donor and the recipient in the pair cultures was inspected under a compound light microscope. After incubation for 3 more days, a mycelial agar plug was removed from the colony of the recipient strain in each of the pair culture petri plates and transferred to a fresh PDA plate containing 40 μg/ml hygromycin B, a medium on which the donor strain BerBc-1 cannot grow. A total of 10 hygromycin-resistant isolates (one each from a pair culture plate) were obtained. The resulting isolates were tested for the presence of BcRV1 using RT-PCR as described above. The BcRV1+ isolates were further tested for growth rates and colony morphology on PDA (20°C, in the dark), for pathogenicity on detached leaves of oilseed rape (20°C, 72 h), and for quantification of BcRV1 accumulation using the methods described above. Strains BerBc-1, AT1C001, and AT910 were used as controls in these tests. In order to further ascertain that the derived hph+ and BcRV1+ strains were indeed due to transmission of BcRV1 from the donor to the recipient and not due to any possibility of contamination, the genetic backgrounds of all the derived hph+ and BcRV1+ isolates, along with isolates BerBc-1, AT1C001, and AT910, were profiled by randomly amplified polymorphic DNA (RAPD) using the 10-mer primer OPW04 (Operon Technologies, Alameda, CA, USA) (see Table S1 in the supplemental material).
To demonstrate the effect of BcRV1 transmission on mycelial growth of B. cinerea, an additional horizontal transmission experiment was carried out using isolate AT910-b as the donor and isolate AT910 as the recipient. There were five replicate plates each for the pair culture AT910-b/AT910 and for single-isolate cultures of isolate AT910 and isolate AT910-b. The cultures were incubated at 20°C in the dark, with daily observations of mycelial growth. After incubation for 7 days, a mycelial agar plug was removed from the colony of isolate AT910 in each pair culture to establish a derivative isolate, for a total of five derivative isolates (AT910-1 to AT910-5). The derivative isolates were individually tested for the presence of BcRV1, growth and colony morphology on PDA, and pathogenicity on oilseed rape using the methods described above.
Statistical analysis.
Data on mycelial growth rates, leaf lesion diameters, and the relative BcRV1 accumulation for different strains of B. cinerea were analyzed using analysis of variance (ANOVA) in SAS (version 8.1; SAS Institute, Cary, NC, USA). Mean values for different strains were compared and separated using Duncan's multiple-range test with significance set at P values of <0.05. Meanwhile, the procedure Univariate in the SAS software was used to analyze the data collected in the horizontal transmission experiment. Mean values between each hph transformant and its parent or between each BcRV1-transmitted isolate and its progenitor strain were compared using Student's t test at P values of <0.05 or <0.01.
Nucleotide sequence accession number.
The full-length cDNA sequence of 8,952 bp of BcRV1 was deposited in GenBank and assigned accession number KJ549662.
RESULTS
Detection and nucleotide sequence of BcRV1.
Three strains of B. cinerea (BerBc-1, LagBc-1, and RoseBc-3) were analyzed for presence of dsRNAs. DsRNAs were detected in strains BerBc-1 and LagBc-1 but not in strain RoseBc-3 (Fig. 1A). Strain BerBc-1 had a dsRNA of approximately 10 kb in size, whereas strain LagBc-1 had three dsRNAs (dsRNA1, dsRNA2, and dsRNA3) of approximately 15.0, 5.5, and 4.4 kb in size, respectively.
FIG 1.
Detection of dsRNA elements in strains BerBc-1, LagBc-1, and RoseBc-3 of Botrytis cinerea by agarose gel electrophoresis (A) and by Northern hybridization (B). The dsRNA extracts were treated with S1 nuclease before electrophoresis. Note one dsRNA of approximately 10.0 kb in BerBc-1 (BcRV1), three dsRNAs of approximately 15.0 kb (dsRNA1), 5.5 kb (dsRNA2), and 4.4 kb (dsRNA3) in LagBc-1, and no dsRNA in RoseBc-3. The 717-bp DNA probe targeting the RdRp region (nt 6329 to 7045) in the genome of BcRV1 was generated from the dsRNA by RT-PCR.
The 10-kb dsRNA in strain BerBc-1 was cDNA cloned, and the sequences of the overlapped cDNA clones were assembled. After filling in the gaps and determining the terminal sequences with additional RT-PCR and sequencing, a full-length cDNA sequence of 8,952 bp of BcRV1 was obtained (see Fig. S1 in the supplemental material) and deposited in GenBank as indicated above. Authenticity of the determined cDNA sequence representing the 10-kb dsRNA of BcRV1 was confirmed by Northern hybridization with a 717-bp DNA probe derived from the cDNA sequence of BcRV1 (nt 6329 to 7045) (Fig. 1B).
Analysis of the cDNA sequence of BcRV1 indicated that there are two open reading frames (ORFs), ORF1 and ORF2, on the positive strand (Fig. 2A). ORF1 is located at nt 879 to 4823. ORF2, if counted from the first in-frame start codon AUG (nt 4871 to 4873), does not overlap ORF1 and is located at nt 4871 to 8887. When the in-frame codons before the start codon are counted, ORF2 (nt 4805 to 8887) has a 19-bp overlap with ORF1. A candidate shifty heptamer (G AAA AAC, nt 4814 to 4820) was found immediately before the stop codon UAG (nt 4821 to 4823) of ORF1 (Fig. 2A and B). A hairpin (H)-type pseudoknot structure (nt 4828 to 4871) was predicted shortly downstream of the shifty heptamer (Fig. 2B and C). A heptanucleotide spacer is located between the shifty heptamer and the pseudoknot (Fig. 2B). The 5′- and 3′-terminal regions were predicted to be capable of forming two stem-loop structures (Fig. 2D).
Putative polypeptides encoded by BcRV1.
The ORF1 of BcRV1 was deduced to encode a hypothetical polypeptide named P1 (Fig. 2A). It contains 1,314 amino acid (aa) residues with an estimated molecular mass of 145 kDa. The sequence of BcRV1 P1 has three motifs (I to III) (Fig. 3) similar to those found in the P1 homologs in seven other dsRNA viruses, including grapevine-associated totivirus 2 (GaTV2) (41), Fusarium graminearum dsRNA mycovirus 3 (FgV3) (42), Fusarium virguliforme dsRNA mycovirus 1 (FvV1) (43), Fusarium virguliforme dsRNA mycovirus 2 (FvV2) (43), Phlebiopsis gigantea mycovirus dsRNA 2 (PgV2) (44), Phytophthora infestans RNA virus 3 (PiRV3) (45), and Sclerotinia sclerotiorum nonsegmented virus L (SsNsV-L) (46). The identity of BcRV1 P1 to the P1 homologs in SsNsV-L (77%) and GaTV2 (93%) is high, whereas to the P1 homologs in the remaining five dsRNA viruses it is low (22 to 45%) (Table 1).
FIG 3.
Multiple alignments of the amino acid sequences of the conserved motifs in the polypeptide P1 and RNA-dependent RNA polymerase (RdRp) encoded by ORF1 and ORF2, respectively, in BcRV1 and related viruses. See legend to Fig. 5 for abbreviations of the virus names.
TABLE 1.
Summary of the BLASTP search results of the polypeptide P1 encoded by ORF1 and RNA-dependent RNA polymerase (RdRp) encoded by ORF2 of Botrytis cinerea RNA virus 1 (BcRV1)
| Search target and virus name (GenBank accession no.)a | Size (aa) | % identity | Overlap (positions) | Bit score | E value |
|---|---|---|---|---|---|
| P1 search | |||||
| GaTV2 (ADO60932) | 1,313 | 93 | 1227/1314 | 2,439 | 0.0 |
| SsNsV-L (YP_006331064) | 1,305 | 77 | 1018/1317 | 2,085 | 0.0 |
| FgV3 (YP_003288788) | 1,369 | 45 | 587/1304 | 1,040 | 0.0 |
| FvV1 (AEZ54147) | 1,311 | 31 | 327/1054 | 378 | 7e−107 |
| FvV2 (AEZ54145) | 1,347 | 32 | 253/794 | 358 | 1e−99 |
| PgV2 (CAJ34334) | 1,696 | 26 | 112/427 | 109 | 5e−21 |
| PiRV3 (AEX87901) | 1,296 | 22 | 124/556 | 71.2 | 2e−09 |
| RdRp search | |||||
| SsNsV-L (YP_006331065) | 1,338 | 71 | 956/1338 | 1,961 | 0.0 |
| GaTV2 (ADO60933)b | >613 | 93 | 571/613 | 1,162 | 0.0 |
| FgV3 (ACY56323) | 1,311 | 45 | 592/1327 | 1,067 | 0.0 |
| FvV1 (AEZ54148) | 1,289 | 33 | 412/1266 | 568 | 8e−176 |
| FvV2 (AEZ54146) | 1,310 | 33 | 426/1274 | 565 | 3e−174 |
| DsRV1 (ACD91658) | 1,110 | 31 | 329/1064 | 410 | 4e−119 |
| PgV2 (CAJ34335) | 1,153 | 37 | 230/614 | 341 | 5e−95 |
| PiRV3 (AEX87902) | 1,011 | 32 | 193/605 | 249 | 2e−65 |
See legend to Fig. 5 for abbreviations of the virus names.
The RdRp sequence of GaTV2 is incomplete in the NCBI database.
ORF2, if counted from the first in-frame start codon, was deduced to encode a 1,338-aa polypeptide with an estimated molecular mass of 146 kDa. It has two conserved domains, namely, the RNA-dependent RNA polymerase superfamily 4 domain (RdRp_4) and the phytoreovirus S7 domain (S7) (Fig. 2A). The BcRV1 RdRp has eight motifs (I to VIII) (Fig. 3), which are conserved in the RdRps in Diplodia scrobiculata RNA virus 1 (DsRV1) (47), FgV3, FvV1, FvV2, PgV1, PgV2, PiRV3, and SsNsV-L. The BcRV1 RdRp shows high identity to the SsNsV-L RdRp (71%) and the partial GaTV2 RdRp (93%) but shows low identity (23 to 45%) to the RdRps of the remaining five RNA mycoviruses mentioned above (Table 1). The BcRV1 S7 domain is 77 aa long (aa 901 to 977). Homologous polypeptides of S7 were also identified in DsRV1, FgV3, FvV1, FvV2, PgV2, and SsNsV-L (Table 2).
TABLE 2.
Comparison of Botrytis cinerea RNA virus 1 (BcRV1) and related viruses in genome size and other putative structuresa
| Virus name (GenBank accession no.)b | Genome (bp) | ORF1 | ORF2 | Size of 5′ UTR (bp) | Size of 3′ UTR (bp) | S7 | Shifty heptamer sequence | Spacer (nt) | Pseudoknot |
|---|---|---|---|---|---|---|---|---|---|
| BcRV1 (KJ549662) | 8,952 | HP | RdRp | 878 | 66 | + | GAAAAAC | 7 | + |
| GaTV2 (GU108594) | >6,595 | HP | RdRp | >765 | ND | ND | GAAAAAC | 7 | + |
| SsNsV-L (JQ513382) | 9,124 | HP | RdRp | 1,088 | 54 | + | GAAAAAC | 14 | + |
| FgV3 (GQ140626) | 9,098 | HP | RdRp | 865 | 44 | + | GAAAAAC | 2 | + |
| FvV1 (JN671444) | 9,402 | SP | RdRp | 1,267 | 45 | + | AAAAAAC | 43 | + |
| FvV2 (JN671443) | 9,327 | SP | RdRp | 1,043 | 131 | + | AAAAAAC | 24 | + |
| PgV2 (AM111097) | >8,727 | HP | RdRp | ND | 47 | + | GGAAAAC | 6 | + |
| PiRV3 (JN603241) | 8,112 | HP | RdRp | 848 | 65 | − | GUUAAAC | 12 | + |
| DsRV1 (EU547739) | 5,018 | HP | RdRp | 29 | 186 | + | − | − | − |
Abbreviations and symbols: ORF, open reading frame; ND, not detected due to the incomplete genome sequence; HP, hypothetical protein; SP, structural protein; UTR, untranslated region; + or −, presence or absence of a certain structure, respectively.
See the legend to Fig. 5 for abbreviations of the virus names.
KNOT-mediated frameshifting.
The plasmids pET-28a(+)-RKG, pET-28a(+)-dsRed, and pET-28a(+)-eGFP, containing dsRed-KNOT-eGFP, dsRed, and eGFP, respectively (see Fig. S2 in the supplemental material), were separately transformed into E. coli. Production of the proteins RFP-GFP, RFP, or GFP under the induction by IPTG was detected by the anti-RFP antibody or the anti-GFP antibody. Results showed that the anti-RFP antibody positively detected RFP in pET-28a(+)-dsRed-transformed E. coli but failed to detect GFP in pET-28a(+)-eGFP-transformed E. coli (Fig. 4A). Similarly, the anti-GFP antibody positively detected GFP in pET-28a(+)-eGFP-transformed E. coli but failed to detect RFP in pET-28a(+)-dsRed-transformed E. coli (Fig. 4B). Therefore, the two antibodies were highly specific in the detection of corresponding targeted proteins. Both antibodies positively detected the 61-kDa protein in pET-28a(+)-RKG-transformed E. coli (Fig. 4), suggesting production of the fusion protein RFP-GFP in the pET-28a(+)-RKG-transformed E. coli. Moreover, the anti-RFP antibody detected very strong hybridization signals for RFP in the pET-28a(+)-RKG-transformed E. coli (Fig. 4A). This result implies that translation of dsRed to RFP may usually terminate at the stop codon in the spacer region of the KNOT element (see Fig. S2A in the supplemental material), thus resulting in high accumulation of RFP. On the other hand, the anti-GFP antibody detected very weak hybridization signals for GFP in pET-28a(+)-RKG-transformed E. coli (Fig. 4B). This result implies that translation of eGFP to GFP might be a rare event. Collectively, these results suggest that the KNOT element in BcRV1 can mediate −1 ribosomal frameshifting, resulting in fused transcription of dsRed and eGFP in E. coli transformed with pET-28a(+)-RKG.
FIG 4.
Western blot detection of the proteins RFP (red fluorescent protein) and GFP (green fluorescent protein) and RFP-GFP fusion in E. coli transformed with the plasmid pET-28a(+)-dsRed (dsRed), pET-28a (+)-eGFP (eGFP), or pET-28a(+)-RKG (RKG) using the anti-RFP antibody (A) or the anti-GFP antibody (B). The symbols “+” and “−” indicate induction and noninduction of the E. coli cultures by IPTG, respectively. Hollow arrows indicate the proteins possibly degraded from the fusion protein RFP-GFP, and the gray arrow indicates the proteins possibly degraded from RFP.
Phylogenetic analysis.
A phylogenetic tree was inferred based on the eight conserved motifs of the RdRp sequences of BcRV1 and 38 selected other RNA viruses (Fig. 5). BcRV1 and seven other taxonomically unassigned dsRNA mycoviruses, including DsRV1, FgV3, FvV1, FvV2, PgV2, PiRV3, and SsNsV-L, formed a distinct clade with 100% bootstrap support. This clade is closely related to the clades for Totiviridae, Quadriviridae, and an unassigned virus group accommodating CiTV1 (Circulifer tenellus virus 1) and SpFV1 (Spissistilus festinus virus 1). However, it is distantly related to the clades for Chrysoviridae and Megabirnaviridae. Results also showed that within the BcRV1 clade, BcRV1 appears to be more closely related to SsNsV-L than to the other six mycoviruses. GaTV2 was not included in the phylogenetic analysis, due to its incomplete RdRp sequence (Fig. 3; Table 1).
FIG 5.
Phylogenetic analysis of BcRV1 (marked by a star) and 38 related RNA viruses. The maximum likelihood tree was inferred from the conserved motifs of RdRp using the WAG+G+I model in MEGA 5.2.2. The percentage values at the nodes in the tree indicate bootstrap support in 1,000 replicates. Bootstrap values lower than 70% are not shown. Abbreviations of the virus names (GenBank accession numbers) are as follows: ACDACV, Amasya cherry disease-associated chrysovirus (CAG77602); AMAV, anthurium mosaic-associated virus (ACU11563); AfuCV, Aspergillus fumigatus chrysovirus (CAX48749); BbV1, Beauveria bassiana virus 1 (CCC42235); BcRV1, Botrytis cinerea RNA virus 1 (AIW58875); BRVF, black raspberry virus F (YP_001497151); CiTV1, Circulifer tenellus virus 1 (YP_003800003); CmRV, Coniothyrium minitans RNA virus (AAO14999); CnCV1, Cryphonectria nitschkei chrysovirus 1 (ACT79255); DsRV1, Diplodia scrobiculata RNA virus 1 (ACD91658); EbRV1, Eimeria brunetti RNA virus 1 (AAK26438); EfV1, Epichloë festucae virus 1 (CAK02788); FgV3, Fusarium graminearum dsRNA mycovirus 3 (ACY56323); FoCV1, Fusarium oxysporum chrysovirus 1 (ABQ53134); FvV1, Fusarium virguliforme dsRNA mycovirus 1 (AEZ54148); FvV2, Fusarium virguliforme dsRNA mycovirus 2 (AEZ54146); GACV1, grapevine-associated chrysovirus 1 (ADO60926); HmTV1-17, Helicobasidium mompa dsRNA virus 17 (BAC81754); HvV145S, Helminthosporium victoriae 145S virus (YP_052858); LRV2-1, leishmania RNA virus 2-1 (AAB50031); LeV-HKB, Lentinula edodes mycovirus HKB (AEB96150); MoCV1, Magnaporthe oryzae chrysovirus 1 (BAJ15133); MoV1, Magnaporthe oryzae virus 1 (BAD60833); PcV, Penicillium chrysogenum virus (AAM95601); PgV1, Phlebiopsis gigantea mycovirus dsRNA 1 (CAJ34333); PgV2, Phlebiopsis gigantea mycovirus dsRNA 2 (CAJ34335); PiRV3, Phytophthora infestans RNA virus 3 (AEX87902); RnMBV1, Rosellinia necatrix megabirnavirus 1 (BAI48016); RnQV1, Rosellinia necatrix quadrivirus 1 (BAL46425); ScVL-A, Saccharomyces cerevisiae virus L-A (AAA50508); SsNsV-L, Sclerotinia sclerotiorum nonsegmented virus L (YP_006331065); SsRV1, Sphaeropsis sapinea RNA virus 1 (AAD11601); SsRV2, Sphaeropsis sapinea RNA virus 2 (AAD11603); SpFV1, Spissistilus festinus virus 1 (YP_003800001); TvV1, Trichomonas vaginalis virus 1 (AAA62868); TvV2, Trichomonas vaginalis virus 2 (AAF29445); TvV4, Trichomonas vaginalis virus 4 (AED99794); UmVH1, Ustilago maydis virus H1 (AAA81884); VdCV1, Verticillium dahliae chrysovirus 1 (ADG21213).
Vertical transmission of BcRV1.
A total of 133 single-conidium (SC) isolates were obtained from the macroconidia from a PDA culture of strain BerBc-1. Based on lesion diameters on leaves of oilseed rape, the SC isolates were classified into four groups (A to D) comprising 37, 73, 21, and 2 isolates, respectively (Fig. 6). Group A isolates caused no visible leaf lesions. The isolates in groups B and C caused medium-sized lesions with average diameters ranging from 0.03 to 5.0 mm and from 5.1 to 13.0 mm, respectively. Two group D isolates, 1C001 and 1C002, caused large lesions with average diameters of 20.8 and 18.5 mm, respectively, similar to lesions caused by the isolate RoseBc-3 (BcRV1−).
FIG 6.
Lesion diameters caused by strains BerBc-1 and RoseBc-3 and the 133 single-conidium isolates generated in the vertical transmission experiment of strain BerBc-1 of Botrytis cinerea on detached leaves of oilseed rape (20°C, 72 h). Note the four pathogenicity groups (A to D) of single-conidium isolates.
Eight SC isolates (1C001, 1C002, 1C004, 1C008, 1C011, 1C014, 1C017, and 1C072) with different pathogenicities were selected to represent the four pathogenicity groups for determination of BcRV1 accumulation, with strains BerBc-1 and RoseBc-3 as positive and negative controls, respectively. Six of the eight SC isolates (1C004, 1C008, 1C011, 1C014, 1C017, and 1C072) had relative BcRV1 accumulation values ranging from 0.78 to 3.79 (the BcRV1 accumulation value in strain BerBc-1 was treated as 1.0) (Fig. 7). The remaining two SC isolates (1C001 and 1C002) had negligible BcRV1 accumulation, with relative accumulation values of 0.02 and 0.03, respectively (Fig. 7). No BcRV1 accumulation was detected in strain RoseBc-3 (Fig. 7). Therefore, BcRV1 in strain BerBc-1 can be vertically transmitted to the next generation through asexual spore macroconidia.
FIG 7.
Mycelial growth rates and relative BcRV1 accumulation levels in strains BerBc-1 and RoseBc-3 and eight single-conidium isolates selected to represent the four pathogenicity groups (A to D) of the initial 133 isolates of strain BerBc-1. There were five replicates for testing mycelial growth rates and three biological replicates for determining BcRV1 accumulation levels. Different letters labeling the means ± standard errors in each histogram indicate significant differences (P < 0.05) according to Duncan's multiple-range test.
The BcRV1 accumulation levels for all the representative SC isolates except isolate 1C008 appeared to be negatively correlated with their average leaf lesion sizes on oilseed rape and mycelial growth rates on PDA (Fig. 6 and 7). Isolates 1C011, 1C014, and 1C072 had high levels of BcRV1 accumulation. They were hypovirulent on oilseed rape and grew slowly on PDA. In contrast, isolates 1C001, 1C002, 1C004, and 1C017 had low-to-medium levels of BcRV1 accumulation. They were highly virulent on oilseed rape and grew rapidly on PDA.
Horizontal transmission of BcRV1.
The recipient isolates 1C001 and RoseBc-3 were labeled with hygromycin resistance by transformation with the hph gene. Two hph+ isolates (AT1C001 and AT910) that exhibited growth and colony morphology and pathogenicity similar to those of their respective progenitor strains (see Fig. S3 in the supplemental material) were selected from a pool of 20 initial transformants for this experiment. These two isolates were used as recipients for BcRV1 in pair cultures with the donor isolate BerBc-1 on PDA at 20°C (see Fig. S4 in the supplemental material). After incubation for 7 days, the two colonies in each pair culture had grown in contact (see Fig. S4 and S5 in the supplemental material). In the pair culture BerBc-1/AT1C001, the two colonies merged without forming any brownish barrage zones in the interaction areas. Hyphal anastomosis in the interaction zones was frequently observed (see Fig. S5 in the supplemental material). In contrast, in the pair culture BerBc-1/AT910, a brownish barrage zone was formed between the two colonies in the interaction areas. Signs of hyphal incompatibility characterized by cell lysis and cytoplasm exudation were frequently observed in the interaction areas (see Fig. S5 in the supplemental material). Hyphal anastomosis between BerBc-1 and AT910 was only occasionally observed.
A total of 10 derivative isolates were obtained from the two recipient colonies in the pair cultures of BerBc-1/AT1C001 and BerBc-1/AT910: 5 isolates from the colonies of AT1C001 (AT1C001-a to AT1C001-e, hph+) and the other 5 isolates from the colonies of AT910 (AT910-a to AT910-e, hph+). Four (AT1C001-d, AT910-b, AT910-c, and AT910-e) of the 10 derived isolates were detected to be BcRV1 positive (Fig. 8A), whereas the remaining 6 isolates were detected to have negligible BcRV1 accumulation (data not shown). The four hph+ BcRV1+ isolates showed RAPD profiles that were the same as those of their corresponding progenitors, suggesting that these BcRV1+ isolates were not from contamination (see Fig. S6 in the supplemental material).
FIG 8.

Relative BcRV1 accumulation levels (A), leaf lesion diameters (B), and mycelial growth rates (C) of different isolates of Botrytis cinerea (the horizontal transmission experiment). The symbols “*” and “**” indicate significant differences between a BcRV1-transmitted isolate and its progenitor at P < 0.05 and P < 0.01, respectively, according to Student's t test.
Isolate AT1C001-d had a relative BcRV1 accumulation value of 0.42 (Fig. 8A). Although it was similar to its progenitor AT1C001 in both growth rate and colony morphology (Fig. 8C; see also Fig. S7 in the supplemental material), it caused lesion sizes significantly (P < 0.01) smaller than those caused by its progenitor (23.1 mm versus 28.5 mm) (Fig. 8B). Therefore, BcRV1 can significantly attenuate virulence even in the absence of obvious adverse effects on growth and colony morphology of its host strain.
Isolates AT910-b, AT910-c, and AT910-e had relative BcRV1 accumulation values of 1.94, 0.53, and 0.76, respectively (Fig. 8A). Isolate AT910-b was severely attenuated in pathogenicity, causing leaf lesions with an average diameter of 5.7 mm, which was significantly smaller (P < 0.01) than that of its progenitor AT910 (19.1 mm) (Fig. 8B). AT910-b was also severely attenuated in mycelial growth and formed abnormal colonies with sectored colony margin (Fig. 8 and 9). In contrast, AT910-c and AT910-e were slightly attenuated in pathogenicity, with average leaf lesion diameters of 17.1 and 16.8 mm, respectively, although the values were still significantly different (P < 0.05) from those of AT910 (19.1 mm) (Fig. 8B). They formed normal colonies without any signs of growth attenuation (Fig. 8C; see also Fig. S7 in the supplemental material). These results suggest that the BcRV1 accumulation values in isolates AT910-b, AT910-c, and AT910-e are negatively correlated to their pathogenicity and mycelial growth.
FIG 9.
Horizontal retransmission of BcRV1 from isolate AT910-b to isolate AT910 through hyphal contact. Top row, two single cultures of isolates AT910 and AT910-b, respectively, and a pair culture of AT910-b/AT910 on PDA (20°C, 7 days). The white star in the pair culture indicates the area where a mycelial agar plug was taken for generation of a derivative isolate of AT910. Note the suppressed growth of isolate AT910 in the pair culture with formation of the sectored colony margin compared to normal growth of this isolate in the single culture. Middle row, PDA cultures (20°C, 15 days) of isolates AT910 and AT910-b and five derivative isolates generated from isolate AT910 in the pair cultures of AT910-b/AT910. Note the formation of abnormal colonies with suppressed growth of isolate AT910-b and five derivative isolates of isolate AT910. Bottom row, pathogenicity of isolates AT910 and AT910-b and five derivative isolates of isolate AT910 on detached leaves of oilseed rape (20°C, 72 h). Note the absence of visible necrotic leaf lesions caused by isolate AT910-b and five derivative isolates of AT910.
The pair cultures of AT910-b/AT910 directly showed the adverse effect of BcRV1 transmission on mycelial growth of AT910 (Fig. 9). Five BcRV1-transmitted isolates (AT910-1 to AT910-5) were severely attenuated in growth on PDA, with formation of abnormal colonies, and in pathogenicity, with inability to cause visible necrotic leaf lesions on oilseed rape (Fig. 9).
DISCUSSION
In this study, we characterized the molecular features of Botrytis cinerea RNA virus 1 (BcRV1) in the hypovirulent strain BerBc-1 of B. cinerea. BcRV1 has a genome of 8,952 bp in length. The genome size is larger than those of six previously sequenced RNA mycovirus genomes in B. cinerea, including BcMV1 (24), Bc378V1 (20), BVF (17), BVX (18), BfTV1 (GenBank accession no. AM491608), and BfPV1 (GenBank accession no. AM491610). Moreover, BcRV1 was deduced to contain two overlapped ORFs and a −1 frameshifting element (Fig. 2). This type of genetic structure is also different from those found in the other six RNA mycoviruses mentioned above. Therefore, BcRV1 is a new RNA mycovirus member in B. cinerea.
The genetic structure of BcRV1 appears to be similar to that in seven other taxonomically unassigned dsRNA viruses, including GaTV2, FgV3, FvV1, FvV2, PgV2, PiRV3, and SsNsV-L (Table 2). BcRV1 was deduced to encode two polypeptides, P1 (from ORF1) and RdRp (from ORF2). The BcRV1 P1 is similar, with 22 to 93% identity, to the P1 homologs in GaTV2, FgV3, FvV1, FvV2, PgV2, PiRV3, and SsNsV-L (Table 1). The BcRV1 RdRp is similar, with 32 to 93% identity, to the RdRps in these mycoviruses (Table 1). In the phylogenetic tree inferred from the RdRp sequences, seven dsRNA mycoviruses, i.e., BcRV1 and six of the seven above-mentioned mycoviruses, and DsRV1 formed a distinct clade (Fig. 5). These comparisons suggest that BcRV1 belongs to the unassigned dsRNA mycovirus group, which may represent a new mycovirus family.
BcRV1 is most closely related to SsNsV-L, infecting S. sclerotiorum, a close relative of B. cinerea. Both mycoviruses are similar in genome size (8,952 and 9,124 bp for BcRV1 and SsNsV-L, respectively), size of P1 (1,314 and 1,305 aa for BcRV1 and SsNsV-L, respectively), and size of RdRp (1,338 aa for each of the two). Moreover, the deduced amino acid sequences of P1 and RdRp are 77 and 71% identical, respectively, for these two mycoviruses (Table 1). These comparisons suggest that BcRV1 and SsNsV-L may belong to the same virus genus. However, BcRV1 and SsNsV-L have different effects on the pathogenicity of their host fungi. BcRV1 caused hypovirulence, as shown in this study, whereas SsNsV-L did not cause hypovirulence in strain Sunf-M of S. sclerotiorum (46).
GaTV2 is a virus found by 454 high-throughput sequencing of the grapevine-associated dsRNAs recovered from grapevine (Vitis vinifera) (41), a plant that is a natural host of B. cinerea. The true host of GaTV2 remains unknown. This study showed that BcRV1 and GaTV2 have the same genetic structure (Table 2). The BcRV1 P1 (1,314 aa) is 93% identical to the GaTV2 P1 (1,313 aa) (Table 1). The BcRV1 RdRp (1,338 aa) is also 93% identical to the partial GaTV2 RdRp (613 aa) (Table 1). Therefore, BcRV1 and GaTV2 might represent two variants of the same virus species. The current study provides the complete RdRp sequence and its natural host fungus.
Programmed −1 ribosomal frameshifting is a common translational recoding mechanism in RNA viruses as well as in other organisms (36). A typical −1 frameshifting sequence comprises three parts, namely, a slippery site (or shifty heptamer), a pseudoknot, and a spacer region between the slippery site and the pseudoknot. The slippery site is the place where frameshifting occurs. It has the general heptanucleotide form X XXY YYZ, where X, Y, and Z represent nucleotides and can even be the same nucleotides (36). Dinman et al. (48) reported that the first three nucleotides of the shifty heptamer in the totivirus Saccharomyces cerevisiae virus L-A (ScVL-A) greatly affect the ribosomal frameshifting efficiency in expression of ScVL-A. Three pyrimidines (e.g., UUU or CCC) have higher frameshifting efficiencies than three purines (e.g., AAA or GGG) in ScVL-A. The pseudoknot is a structure capable of inducing the translating ribosomes on the RNA template to pause, thus enhancing the possibility of ribosomal frameshifting (36, 37). The classical H-type pseudoknot requires pairing of the loop of a hairpin structure with the downstream sequence, thus forming two loops and two loop-connected stems (Fig. 2C). The length and the strength of the two stems also impact the frameshifting efficiency in ScVL-A (49, 50). The spacer region between the slippery site and the pseudoknot is also crucial for ribosomal frameshifting, and the optimum spacer length is 6 to 9 nt long (36, 49, 51). In this study, a −1 frameshifting sequence with the heptamer-spacer-pseudoknot structure was identified in the genome of BcRV1 (Fig. 2B). Similar frameshifting structures have been identified in seven relatives of BcRV1, including FgV3, FvV1, FvV2, GaTV2, PgV2, PiRV3, and SsNsV-L (Table 2). BcRV1 and three relatives (FgV3, GaTV2, and SsNsV-L) have the same shifty heptamers (G AAA AAC). Moreover, both BcRV1 and GaTV2 have the 7-nt-long spacer. In contrast, BcRV1 differs from the four relatives (FvV1, FvV2, PgV2, and PiRV3) in the shifty heptamer sequence and from the six relatives (FgV3, FvV1, FvV2, PgV2, PiRV3, and SsNsV-L) in spacer length. These comparative results are consistent with the result from the RdRp-based phylogenetic analysis. Interestingly, the first three nucleotides in the shifty heptamers for BcRV1 and its relatives are variable (GAA in BcRV1, FgV3, GaTV2, and SsNsV-L; AAA in FvV1 and FvV2; GGA in PgV2; and GUU in PiRV3), whereas the last four nucleotides (AAAC) in the shifty heptamers are highly conserved. Further studies are necessary to elucidate the effects of different shifty heptamers and/or different spacer length on frameshifting efficiencies in BcRV1 and other RNA viruses.
The E. coli expression system has been used in previous studies for analysis of ribosomal frameshifting in viruses infecting yeasts (50) and plants (51). In this study, the role of the −1 frameshifting sequence (here designated the KNOT element) was confirmed by expression of the plasmid pET-28a(+)-RKG containing the construct dsRed-KNOT-eGFP in E. coli. Consistent detection of the fusion protein RFP-GFP in E. coli using specific antibodies (Fig. 4) suggests that the KNOT element can mediate expression of the large ORF for dsRed-KNOT-eGFP to produce the fusion protein RFP-GFP (see Fig. S2A in the supplemental material). However, whether or not the KNOT element can mediate −1 frameshifting to produce the fusion protein P1-RdRp in strain BerBc-1 remains unknown. Salaipeth and colleagues (52) used a Western blotting technique to detect the −1 frameshifting strategy for expression of the coat protein and RdRp in Rosellinia necatrix megabirnavirus 1 (RnMBV1) in C. parasitica. This technique might be useful in future studies to determine the expression strategy for BcRV1 P1 and RdRp in BcRV1-infected B. cinerea.
Three lines of evidence are presented to show that BcRV1 is closely associated with hypovirulence of B. cinerea in a dose-dependent manner. First, the BcRV1-infected strain BerBc-1 is hypovirulent on oilseed rape, whereas strain RoseBc-3 free of BcRV1 and other mycoviruses is virulent on this crop (Fig. 6). Second, six (1C004, 1C008, 1C011, 1C014, 1C017, and 1C072) of the eight single-conidium isolates of BerBc-1, which showed BcRV1 accumulation, were hypovirulent (Fig. 6 and 7), whereas the other two SC isolates (1C001 and 1C002), which showed negligible BcRV1 accumulation, became highly virulent (Fig. 6 and 7). Third, the three derived hph+ and BcRV1+ isolates (AT910-b, AT910-c, and AT910-e) generated in the horizontal transmission experiment showed various levels of BcRV1 accumulation and also various levels of pathogenicity (Fig. 8). The BcRV1 accumulation levels were negatively correlated with their virulence among the isolates of the same genetic background. Despite the strong evidence of negative correlation, a cause-effect relationship between BcRV1 infection and hypovirulence still needs to be further ascertained in future studies. Two methods, the virion transfection method and the infectious viral cDNA method, have been successfully used in previous studies to elucidate the cause-effect relationship between mycovirus infection and fungal hypovirulence (3, 15, 25, 31, 53). These approaches might be useful in future studies for determination of the causal effect of BcRV1 on hypovirulence in B. cinerea.
Strain BerBc-1 was able to produce both macroconidia and microconidia on PDA at 20°C. However, the microconidia did not germinate (data not shown). Therefore, we did not assess the possibility of vertical transmission of BcRV1 through microconidia. Microconidia were previously shown to act as spermatia in sexual reproduction of the heterothallic B. cinerea (54, 55). Thus, unless techniques for germinating microconidia become available, future studies could employ the microconidia of strain BerBc-1 to fertilize sclerotia of BcRV1− strains of B. cinerea to assess the potential of vertical transmission via microconidia.
Strains BerBc-1 and AT910 showed incompatibility in the pair cultures due to formation of brownish barrage zones and hyphal cytoplasm exudation in the interaction areas of the two colonies (see Fig. S4 and S5 in the supplemental material). In spite of the hyphal incompatibility, hyphal anastomosis was occasionally observed. Successful transmission of BcRV1 from strain BerBc-1 to strain AT910 might be through the occasional hyphal anastomosis. This virus transmission strategy might be useful for future exploitation of BcRV1 to control B. cinerea.
In conclusion, this study characterized the biological and molecular features of BcRV1 in B. cinerea. BcRV1 belongs to a taxonomically unassigned dsRNA mycovirus group. BcRV1 can be transmitted vertically through asexual spore macroconidia and horizontally to other strains of B. cinerea through hyphal contact. BcRV1 is closely associated with hypovirulence of B. cinerea. The BcRV1 accumulation level greatly affects the attenuation effect of BcRV1 on the pathogenicity of B. cinerea.
Supplementary Material
ACKNOWLEDGMENTS
This research was funded by the R & D Special Fund for Public Welfare Industry (Agriculture) of China (grant number 201303025) and the National Natural Science Foundation of China (grant numbers 31070122 and 31301615).
Footnotes
Supplemental material for this article may be found at http://dx.doi.org/10.1128/AEM.03992-14.
REFERENCES
- 1.Ghabrial SA, Suzuki N. 2009. Viruses of plant pathogenic fungi. Annu Rev Phytopathol 47:353–384. doi: 10.1146/annurev-phyto-080508-081932. [DOI] [PubMed] [Google Scholar]
- 2.Pearson MN, Beever RE, Boine B, Arthur K. 2009. Mycoviruses of filamentous fungi and their relevance to plant pathology. Mol Plant Pathol 10:115–128. doi: 10.1111/j.1364-3703.2008.00503.x. [DOI] [PMC free article] [PubMed] [Google Scholar]
- 3.Chiba S, Salaipeth L, Lin YH, Sasaki A, Kanematsu S, Suzuki N. 2009. A novel bipartite double-stranded RNA mycovirus from the white root rot fungus Rosellinia necatrix: molecular and biological characterization, taxonomic considerations, and potential for biological control. J Virol 83:12801–12812. doi: 10.1128/JVI.01830-09. [DOI] [PMC free article] [PubMed] [Google Scholar]
- 4.Kondo H, Chiba S, Toyoda K, Suzuki N. 2013. Evidence for negative-strand RNA virus infection in fungi. Virology 435:201–209. doi: 10.1016/j.virol.2012.10.002. [DOI] [PubMed] [Google Scholar]
- 5.Liu L, Xie J, Cheng J, Fu Y, Li G, Yi X, Jiang D. 2014. Fungal negative-stranded RNA virus that is related to bornaviruses and nyaviruses. Proc Natl Acad Sci U S A 111:12205–12210. doi: 10.1073/pnas.1401786111. [DOI] [PMC free article] [PubMed] [Google Scholar]
- 6.Yu X, Li B, Fu YP, Jiang DH, Ghabrial SA, Li GQ, Peng YL, Xie JT, Cheng JS, Huang JB, Yi XH. 2010. A geminivirus-related DNA mycovirus that confers hypovirulence to a plant pathogenic fungus. Proc Natl Acad Sci U S A 107:8387–8392. doi: 10.1073/pnas.0913535107. [DOI] [PMC free article] [PubMed] [Google Scholar]
- 7.Nuss DL. 2005. Hypovirulence: mycoviruses at the fungal-plant interface. Nat Rev Microbiol 3:632–642. doi: 10.1038/nrmicro1206. [DOI] [PubMed] [Google Scholar]
- 8.Anagnostakis SL. 1982. Biological control of chestnut blight. Science 215:466–471. doi: 10.1126/science.215.4532.466. [DOI] [PubMed] [Google Scholar]
- 9.Heiniger U, Rigling D. 1994. Biological control of chestnut blight in Europe. Annu Rev Phytopathol 32:581–599. doi: 10.1146/annurev.py.32.090194.003053. [DOI] [Google Scholar]
- 10.Yu X, Li B, Fu YP, Xie JT, Cheng JS, Ghabrial SA, Li GQ, Yi XH, Jiang DH. 2013. Extracellular transmission of a DNA mycovirus and its use as a natural fungicide. Proc Natl Acad Sci U S A 110:1452–1457. doi: 10.1073/pnas.1213755110. [DOI] [PMC free article] [PubMed] [Google Scholar]
- 11.Williamson B, Tudzynski B, Tudzynski P, van Kan JAL. 2007. Botrytis cinerea: the cause of gray mould disease. Mol Plant Pathol 8:561–580. doi: 10.1111/j.1364-3703.2007.00417.x. [DOI] [PubMed] [Google Scholar]
- 12.Fravel DR. 2005. Commercialization and implementation of biocontrol. Annu Rev Phytopathol 43:337–359. doi: 10.1146/annurev.phyto.43.032904.092924. [DOI] [PubMed] [Google Scholar]
- 13.Pearson MN, Bailey AM. 2013. Viruses of Botrytis. Adv Virus Res 86:249–272. doi: 10.1016/B978-0-12-394315-6.00009-X. [DOI] [PubMed] [Google Scholar]
- 14.Castro M, Kramer K, Valdivia L, Ortiz S, Benavente J, Castillo A. 1999. A new double-stranded RNA mycovirus from Botrytis cinerea. FEMS Microbiol Lett 175:95–99. doi: 10.1111/j.1574-6968.1999.tb13606.x. [DOI] [PubMed] [Google Scholar]
- 15.Castro M, Kramer K, Valdivia L, Ortiz S, Castillo A. 2003. A double-stranded RNA mycovirus confers hypovirulence-associated traits to Botrytis cinerea. FEMS Microbiol Lett 228:87–91. doi: 10.1016/S0378-1097(03)00755-9. [DOI] [PubMed] [Google Scholar]
- 16.Howitt RLJ, Beever RE, Pearson MN, Forster RLS. 1995. Presence of double-stranded RNA and virus-like particles in Botrytis cinerea. Mycol Res 99:1472–1478. doi: 10.1016/S0953-7562(09)80795-8. [DOI] [Google Scholar]
- 17.Howitt RLJ, Beever RE, Pearson MN, Forster RLS. 2001. Genome characterization of Botrytis virus F, a flexuous rod-shaped mycovirus resembling plant ‘potex-like’ viruses. J Gen Virol 82:67–78. [DOI] [PubMed] [Google Scholar]
- 18.Howitt RLJ, Beever RE, Pearson MN, Forster RLS. 2006. Genome characterization of a flexuous rod-shaped mycovirus, Botrytis virus X, reveals high amino acid identity to genes from plant ‘potex-like’ viruses. Arch Virol 151:563–579. doi: 10.1007/s00705-005-0621-y. [DOI] [PubMed] [Google Scholar]
- 19.Kecskeméti E, Brathuhn A, Kogel KH, Berkelmann-Löhnertz B, Reineke A. 2014. Presence of transposons and mycoviruses in Botrytis cinerea isolates collected from a German grapevine growing region. J Phytopathol 162:582–595. doi: 10.1111/jph.12230. [DOI] [Google Scholar]
- 20.Potgieter CA, Castillo A, Castro M, Cottet L, Morales A. 2013. A wild-type Botrytis cinerea strain co-infected by double-stranded RNA mycoviruses presents hypovirulence-associated traits. Virol J 10:220. doi: 10.1186/1743-422X-10-220. [DOI] [PMC free article] [PubMed] [Google Scholar]
- 21.Rodríguez-García C, Medina V, Alonso A, Ayllón MA. 2014. Mycoviruses of Botrytis cinerea isolates from different hosts. Ann Appl Biol 164:46–61. doi: 10.1111/aab.12073. [DOI] [Google Scholar]
- 22.Vilches S, Castillo A. 1997. A double-stranded RNA mycovirus in Botrytis cinerea. FEMS Microbiol Lett 155:125–130. doi: 10.1111/j.1574-6968.1997.tb12696.x. [DOI] [PubMed] [Google Scholar]
- 23.Wu MD, Zhang L, Li GQ, Jiang DH, Hou MS, Huang HC. 2007. Hypovirulence and double-stranded RNA in Botrytis cinerea. Phytopathology 97:1590–1599. doi: 10.1094/PHYTO-97-12-1590. [DOI] [PubMed] [Google Scholar]
- 24.Wu MD, Zhang L, Li GQ, Jiang D, Ghabrial SA. 2010. Genome characterization of a debilitation-associated mitovirus infecting the phytopathogenic fungus Botrytis cinerea. Virology 406:117–126. doi: 10.1016/j.virol.2010.07.010. [DOI] [PubMed] [Google Scholar]
- 25.Xiao XQ, Cheng JS, Tang JH, Fu YP, Jiang DH, Baker TS, Ghabrial SA, Xie JT. 2014. A novel partitivirus that confers hypovirulence on plant pathogenic fungi. J Virol 88:10120–10133. doi: 10.1128/JVI.01036-14. [DOI] [PMC free article] [PubMed] [Google Scholar]
- 26.Beever RE, Parkes SL. 2003. Use of nitrate non-utilising (Nit) mutants to determine vegetative compatibility in Botryotinia fuckeliana (Botrytis cinerea). Eur J Plant Pathol 109:607–613. doi: 10.1023/A:1024732815134. [DOI] [Google Scholar]
- 27.Korolev N, Elad Y, Katan T. 2008. Vegetative compatibility grouping in Botrytis cinerea using sulphate non-utilizing mutants. Eur J Plant Pathol 122:369–383. doi: 10.1007/s10658-008-9301-6. [DOI] [Google Scholar]
- 28.Cortesi P, McCulloch CE, Song H, Lin H, Milgroom MG. 2001. Genetic control of horizontal virus transmission in the chestnut blight fungus, Cryphonectria parasitica. Genetics 159:107–118. [DOI] [PMC free article] [PubMed] [Google Scholar]
- 29.Ihrmark K, Johannesson H, Stenström E, Stenlid J. 2002. Transmission of double-stranded RNA in Heterobasidion annosum. Fungal Genet Biol 36:147–154. doi: 10.1016/S1087-1845(02)00011-7. [DOI] [PubMed] [Google Scholar]
- 30.Papazova-Anakieva I, Sotirovski K, Cortesi P, Milgroom MG. 2008. Horizontal transmission of hypoviruses between vegetative compatibility types of Cryphonectria parasitica in Macedonia. Eur J Plant Pathol 120:35–42. doi: 10.1007/s10658-007-9191-z. [DOI] [Google Scholar]
- 31.Wu MD, Jin FY, Zhang J, Yang L, Jiang DH, Li GQ. 2012. Characterization of a novel bipartite double-stranded RNA mycovirus conferring hypovirulence in the phytopathogenic fungus Botrytis porri. J Virol 86:6605–6619. doi: 10.1128/JVI.00292-12. [DOI] [PMC free article] [PubMed] [Google Scholar]
- 32.Möller EM, Bahnweg G, Sandermann H, Geiger HH. 1992. A simple and efficient protocol for isolation of high molecular weight DNA from filamentous fungi, fruit bodies, and infected plant tissues. Nucleic Acids Res 20:6115–6116. doi: 10.1093/nar/20.22.6115. [DOI] [PMC free article] [PubMed] [Google Scholar]
- 33.Sperschneider J, Datta A. 2010. DotKnot: pseudoknot prediction using the probability dot plot under a refined energy model. Nucleic Acids Res 38:e103. doi: 10.1093/nar/gkq021. [DOI] [PMC free article] [PubMed] [Google Scholar]
- 34.Darty K, Denise A, Ponty Y. 2009. VARNA: interactive drawing and editing of the RNA secondary structure. Bioinformatics 25:1974–1975. doi: 10.1093/bioinformatics/btp250. [DOI] [PMC free article] [PubMed] [Google Scholar]
- 35.Mathews DH, Disney MD, Childs JL, Schroeder SJ, Zuker M, Turner DH. 2004. Incorporating chemical modification constraints into a dynamic programming algorithm for prediction of RNA secondary structure. Proc Natl Acad Sci U S A 101:7287–7292. doi: 10.1073/pnas.0401799101. [DOI] [PMC free article] [PubMed] [Google Scholar]
- 36.Alam SL, Atkins JF, Gesteland RF. 1999. Programmed ribosomal frameshifting: much ado about knotting. Proc Natl Acad Sci U S A 96:14177–14179. doi: 10.1073/pnas.96.25.14177. [DOI] [PMC free article] [PubMed] [Google Scholar]
- 37.Plant EP, Jacobs KLM, Harger JW, Meskauskas A, Jacobs JL, Baxter JL, Petrov AN, Dinman JD. 2003. The 9-Å solution: how mRNA pseudoknots promote efficient programmed -1 ribosomal frameshifting. RNA 9:168–174. doi: 10.1261/rna.2132503. [DOI] [PMC free article] [PubMed] [Google Scholar]
- 38.Dillon PJ, Rosen CA. 1993. Use of polymerase chain reaction for the rapid construction of synthetic genes. Methods Mol Biol 15:263–268. [DOI] [PubMed] [Google Scholar]
- 39.Livak KJ, Schmittgen TD. 2001. Analysis of relative gene expression data using real-time quantitative PCR and the 2−ΔΔCT method. Methods 25:402–408. doi: 10.1006/meth.2001.1262. [DOI] [PubMed] [Google Scholar]
- 40.Fan L, Zhang J, Yang L, Li GQ. 2013. Agrobacterium tumefaciens-mediated transformation of Botrytis cinerea strain RoseBc-3. J Huazhong Agric Univ 32:1–6. [Google Scholar]
- 41.Al Rwahnih M, Daubert S, Uacute;rbez-Torres J, Cordero F, Rowhani A. 2011. Deep sequencing evidence from single grapevine plants reveals a virome dominated by mycoviruses. Arch Virol 156:397–403. doi: 10.1007/s00705-010-0869-8. [DOI] [PMC free article] [PubMed] [Google Scholar]
- 42.Yu J, Kwon SJ, Lee KM, Son M, Kim KH. 2009. Complete nucleotide sequence of double-stranded RNA viruses from Fusarium graminearum strain DK3. Arch Virol 154:1855–1858. doi: 10.1007/s00705-009-0507-5. [DOI] [PubMed] [Google Scholar]
- 43.Marvelli RA, Hobbs HA, Li SX, McCoppin NK, Domier LL, Hartman GL, Eastburn DM. 2014. Identification of novel double-stranded RNA mycoviruses of Fusarium virguliforme and evidence of their effects on virulence. Arch Virol 159:349–352. doi: 10.1007/s00705-013-1760-1. [DOI] [PubMed] [Google Scholar]
- 44.Kozlakidis Z, Hacker CV, Bradley D, Jamal A, Phoon X, Webber J, Brasier CM, Buck KW, Coutts RHA. 2009. Molecular characterisation of two novel double-stranded RNA elements from Phlebiopsis gigantea. Virus Genes 39:132–136. doi: 10.1007/s11262-009-0364-z. [DOI] [PubMed] [Google Scholar]
- 45.Cai GH, Krychiw JF, Myers K, Fry WE, Hillman BI. 2013. A new virus from the plant pathogenic oomycete Phytophthora infestans with an 8 kb dsRNA genome: the sixth member of a proposed new virus genus. Virology 435:341–349. doi: 10.1016/j.virol.2012.10.012. [DOI] [PubMed] [Google Scholar]
- 46.Liu HQ, Fu YP, Xie JT, Cheng JS, Ghabrial SA, Li GQ, Peng YL, Yi XH, Jiang DH. 2012. Evolutionary genomics of mycovirus-related dsRNA viruses reveals cross-family horizontal gene transfer and evolution of diverse viral lineages. BMC Evol Biol 12:91. doi: 10.1186/1471-2148-12-91. [DOI] [PMC free article] [PubMed] [Google Scholar]
- 47.De Wet J, Bihon W, Preisig O, Wingfield BD, Wingfield MJ. 2011. Characterization of a novel dsRNA element in the pine endophytic fungus Diplodia scrobiculata. Arch Virol 156:1199–1208. doi: 10.1007/s00705-011-0978-z. [DOI] [PubMed] [Google Scholar]
- 48.Dinman JD, Icho T, Wickner RB. 1991. A -1 ribosomal frameshift in a double-stranded RNA virus of yeast forms a gag-pol fusion protein. Proc Natl Acad Sci U S A 88:174–178. doi: 10.1073/pnas.88.1.174. [DOI] [PMC free article] [PubMed] [Google Scholar]
- 49.Dinman JD. 1995. Ribosomal frameshifting in yeast viruses. Yeast 11:1115–1127. doi: 10.1002/yea.320111202. [DOI] [PMC free article] [PubMed] [Google Scholar]
- 50.Tzeng T, Tu C, Bruenn JA. 1992. Ribosomal frameshifting requires a pseudoknot in the Saccharomyces cerevisiae double-stranded RNA virus. J Virol 66:999–1006. [DOI] [PMC free article] [PubMed] [Google Scholar]
- 51.Hansen TM, Reihani SNS, Oddershede LB, Sørensen MA. 2007. Correlation between mechanical strength of messenger RNA pseudoknots and ribosomal frameshifting. Proc Natl Acad Sci U S A 104:5830–5835. doi: 10.1073/pnas.0608668104. [DOI] [PMC free article] [PubMed] [Google Scholar]
- 52.Salaipeth L, Chiba S, Eusebio-Cope A, Kanematsu S, Suzuki N. 2014. Biological properties and expression strategy of rosellinia necatrix megabirnavirus 1 analysed in an experimental host, Cryphonectria parasitica. J Gen Virol 95:740–750. doi: 10.1099/vir.0.058164-0. [DOI] [PubMed] [Google Scholar]
- 53.Choi GH, Nuss DL. 1992. Hypovirulence of chestnut blight fungus conferred by an infectious viral cDNA. Science 257:800–803. doi: 10.1126/science.1496400. [DOI] [PubMed] [Google Scholar]
- 54.Fareta F, Antonacci E. 1987. Production of apothecia of Botryotinia fuckeliana (de Bary) Whetz. under controlled environmental conditions. Phytopathol Medit 26:29–35. [Google Scholar]
- 55.Fukumori Y, Nakajima M, Akutsu K. 2004. Microconidia act the role as spermatia in the sexual reproduction of Botrytis cinerea. J Gen Plant Pathol 70:256–260. doi: 10.1007/s10327-004-0124-9. [DOI] [Google Scholar]
Associated Data
This section collects any data citations, data availability statements, or supplementary materials included in this article.